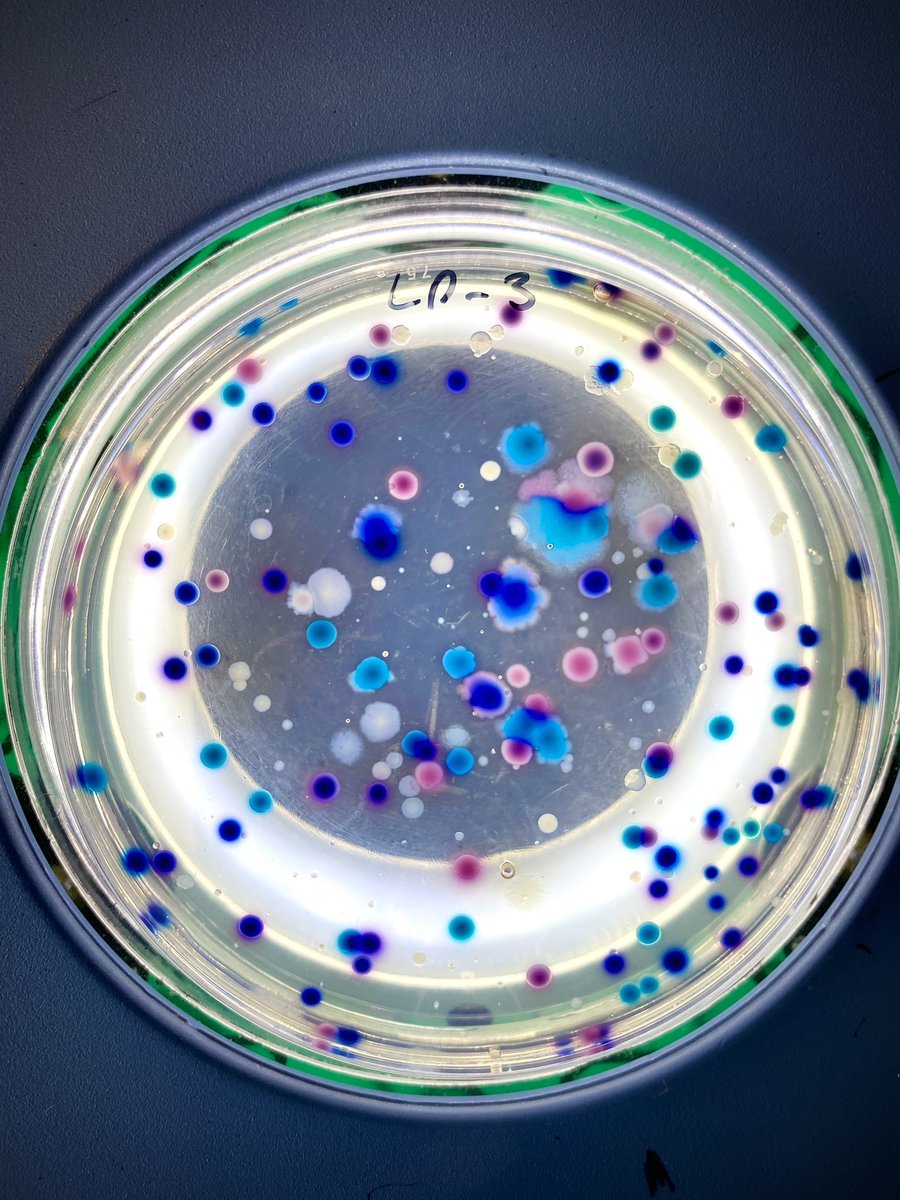
Dr Emily Stevenson tweet media

Samantha Webster retweetledi

⚠️Severe Heatwave Warning for large parts of #Queensland
Maximum temperatures in the low thirties to mid forties. Overnight minimum temperatures in the high teens to high twenties.
Heatwave conditions will gradually contract to the north of the state.
bom.gov.au/qld/warnings/h…

English